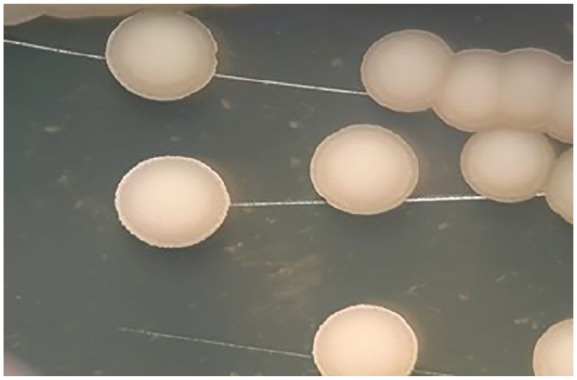

Abstract
Severe pneumonia due to Candida tropicalis infection mainly occurs in immunosuppressed patients or those currently receiving broad-spectrum antibiotics. Herein, we report a case of severe pneumonia caused due to C tropicalis in an elderly patient. A 72-year-old man with a previous history of hypertension, ischemic stroke, and facial paralysis sequelae treated with the botulinic toxin, was admitted to the hospital for dyspnea. Severe acute respiratory syndrome coronavirus 2 (SARS-COV-2) infection was negative. Computed tomography of the chest revealed bilateral consolidation with left predominance. A bronchoalveolar lavage sample was sent to molecular biology, but no microorganisms were detected using a FilmArray respiratory panel. However, mamanocandidas test for candida was 166 pg/mL (positive), and fungal structures were identified by the MALDI-TOF Biotyper mass spectrometry and attributed to C tropicalis. Antifungal therapy was started using caspofungin 75 mg as the initial dose followed by 50 mg daily. After 10 days of treatment, ventilatory weaning was achieved. By day 14, the patient was decannulated from the tracheostomy. Oral antifungal treatment with voriconazole was continued, and he was discharged from intensive care in good clinical condition. Severe pneumonia due to C tropicalis might occur in specific cases, especially in those patients with risk factors, and must thus be considered when approaching such cases.
Keywords: Candida tropicalis, pneumonia, bronchoalveolar lavage, MALDI-TOF Biotyper, FilmArray respiratory panel
Highlights
Severe pneumonia caused due to C tropicalis out-of-hospital presentation is rare.
Severe pneumonia due to C tropicalis might occur in specific cases, such as in patients with the risk factors, especially in immunosuppressed patients or patients receiving broad-spectrum antibiotics.
Almost every patient with severe fungal infection is initially treated as a case of bacterial pneumonia, which leads to poor clinical outcomes and late initiation of antifungal therapy.
Early and fast accurate diagnosis taking into account individual clinical characteristics, bronchoscopy sampling, molecular study, histopathology, and culture, bacterial microbiological techniques as well as more aggressive treatment can lead to better results.
Introduction
Severe pneumonia is a common condition found among patients admitted to the Intensive Care Unit (ICU).1 Pneumonia can be categorized into 3 according to site of acquisition and development: (1) community-acquired pneumonia (CAP), (2) hospital-acquired pneumonia (HAP), and (3) ventilator-associated pneumonia (VAP).2 A wide spectrum of pathogens responsible for pneumonia has been established, with bacteria being the most representative pathogen identified. Bronchoalveolar lavage (BAL) is essential in identifying the pathogen, especially in patients with clinical features very suggestive of pneumonia.
In terms of cause, it remains controversial whether fungal infections have a role in the development of pneumonia. However, fungal pneumonia as a single diagnosis among patients from different communities has been reported in the literature.3 The diagnosis of fungal pneumonia presents a challenge because of its nonspecific clinical features. Moreover, the confirmation of its diagnosis relies on histopathologic tests.4
C tropicalis is a species of Candida adaptable to high temperatures and saline environments. C tropicalis can produce biofilms that are highly adherent to epithelial and endothelial cells, thus giving it the special characteristics of virulence and resistance to the usual antifungal therapy currently available.
Pneumonia due to C tropicalis infection mainly occurs in immunosuppressed patients or patients receiving broad-spectrum antibiotics, and out-of-hospital presentation is rare. Herein, we report a case of severe pneumonia due to C tropicalis in an elderly patient.
Case Report
A 72-year-old male patient, who previously worked as a teacher and cacao farmer, with a previous history of hypertension and ischemic stroke, in addition, the patient had been receiving treatment with botulinic toxin, as a measure to improve facial symmetry, reducing hyperkinesis, and facial imbalance due to the diagnosis of Bell’s palsy. This treatment was provided by a private neurologist from another hospital, we were not provided with previous computed tomography (CT) and magnetic resonance imaging (MRI) studies.
The patient presented at the emergency department to the hospital with and 10-day history of fever, respiratory symptoms, productive cough, occasional chest pain, and dyspnea with hypoxemia (SO2 85%). He has previously received 2 doses of COVID-19 vaccine, and real-time polymerase chain reaction (RT-PCR) for SARS-CoV-2 was negative.
Owing to severe dyspnea and persistent hypoxemia despite administration of oxygen, the patient required orotracheal intubation and mechanical ventilation. Laboratory results upon admission were as follow: white blood cells 11.420/µL (normal value [NV]: 4.000-11.000/µL), neutrophils 94% (NV: 40%-60%), lymphocytes 22.4% (NV: 20%-40%), C-reactive protein (CRP) 38 mg/dL (NV: 0-5 mg/dL), procalcitonin 0.23 (NV: 0.25-0.50 mg/dL), ferritin 118 ng/mL (NV: 12-300 ng/mL), and D-dimer 450 ng/mL (NV: < 500 ng/mL). Chest computed tomography (CT) scan showed bilateral consolidation with left predominance (Figure 1).
Figure 1.

Chest computed tomography (CT) scan showed bilateral consolidation with left predominance.
A diagnosis of severe CAP was made, and empirical antibiotic therapy with cefepime and levofloxacin was started. On hospital day 2, once the patient was hemodynamically stable, fiberoptic bronchoscopy was performed, wherein thick whitish mucous secretions obstructing the bronchial lumen were observed (Figure 2).
Figure 2.

The bronchoscopy image. The bronchoscopy image shows white mucous secretions at the entrance of the left main bronchus and scattered whitish plaques along the bronchial mucosa.
The BAL sample was sent to the molecular biology laboratory, and no microorganisms were detected through a FilmArray respiratory panel and MALDI-TOF Biotyper mass spectrometry. In addition, the BAL samples were negative for Ziehl Neelsen (ZN) stain, GeneXpert MTB/RIF (Xpert), and Löwenstein-Jensen culture for tuberculosis.
On hospital day 4, sedation and ventilator weaning were started; however, atelectasis of the left lung was noted (Figure 3). On hospital day 5, a second fiberoptic bronchoscopy was performed, which yielded similar findings of a thick mucus plug obstructing the bronchial lumen of the right and left pulmonary segments and scattered whitish plaques on the bronchial mucosa. Bronchoalveolar lavage was performed once again, and the samples were sent for bacteriological and fungal study. The following results were obtained: Galactomannan Aspergillus test 0.18 pg/mL (negative), mamanocandidas for Candida 166 pg/mL (positive), and KOH smear with fungal structures compatible with yeasts. In addition, MALDI-TOF Biotyper mass spectrometry identified C tropicalis (Figure 4).
Figure 3.

Atelectasis of the left lung is observed on the chest X-ray.
Figure 4.
Microbiological detection of microorganism: (A) isolated colonies of C tropicalis in Agar Saboraud Dextrose with chloramphenicol. (B) Fresh preparation microscopy and KOH smear show blasticonidia and pseudohyphae typical of C tropicalis. The identification was made by MALDI-TOF Biotyper mass spectrometry version 3.1 of Bruker daltonik GmbH.
Treatment was started with echinocandins, specifically caspofungin 75 mg as an initial dose and then 50 mg daily. Pulmonary biopsy at the level of the carina was taken, and the sample was sent for histopathological study.
By hospital day 7, due to prolonged intubation and failure to wean from the ventilator, surgical tracheostomy was scheduled.
The lung biopsy report revealed the following: surface epithelium had areas of reactive hyperplasia without atypia; the chorion had variable degrees of edema and a discrete quantity of scattered lymphoplasmacytic inflammatory cells, alternating with occasional neutrophils. Few conserved bronchial glands and undamaged paired smooth muscle lamina were also identified.
After 10 days of treatment with caspofungin, ventilatory weaning was finally achieved, without presenting with a new episode of pulmonary atelectasis. By day 14, the patient was decannulated from the tracheostomy. Oral antifungal treatment with voriconazole was continued, and he was discharged from the ICU in good clinical condition.
One month after discharge, a high-resolution CT scan of the chest was performed revealing scarce cylindrical bronchiectasis (Figure 5).
Figure 5.

High-resolution CT scan of the patient. High-resolution CT scan of the chest taken 1 month after discharge shows scarce cylindrical bronchiectasis.
Abbreviation: CT, computed tomography.
Discussion
Herein, we report a case of severe pneumonia caused by C tropicalis, wherein the identification of the pathogen was a diagnostic challenge. The diagnosis of pulmonary candidiasis diagnosis remains controversial. Although the pathogens are mainly isolated from sputum samples and/or BAL samples from bronchoscopy, it is still difficult to determine whether the culture is positive for the pathogen causing pneumonia or if it is simply a contaminant. Even at intensive care units (ICUs), the definitive diagnosis is based on the histological findings of a sterile normal pulmonary tissue, which is hardly available in daily practice with living individuals. Most of these results have been reported in postmortem studies.5
Pneumonia due to Candida is an unusual diagnosis, and it has been exclusively related to severe immunosuppression, malignant tumors, and hematogenous spread from an initial source. As previously mentioned, a definitive diagnosis requires histologic confirmation. In this study, BAL biopsy was performed, but there was no evidence of invasive fungal infection as expected. This could be due to the source of the biopsy, which was at the carina. Other sites of the respiratory tree were not performed for biopsy considering the risk of complications and mortality for the patient.6
Almost every patient with severe fungal infection is initially treated as a case of bacterial pneumonia, which leads to poor clinical outcomes and late initiation of antifungal therapy. Early diagnosis as well as a more aggressive treatment may lead to better outcomes, such as it did with the patient in this report.
The high probability of a fungal cause of the disease was established based on the positive quantitative culture for Candida and the results of the polymerase chain reaction (PCR) performed on 2 bronchoscopy samples. Moreover, there was a lack of response to the initial antibiotic therapy, so treatment was shifted to the antifungals voriconazole and caspofungin.7
C tropicalis causes severe diseases that have been observed in patients with fungal arthritis, and hematological neoplasms, especially neutropenic, with the use of immunosuppressive drugs and previous prolonged use of broad-spectrum antibiotics.8,9 Our patient from the community, who had a history of receiving facial injections treatment of botulinum toxin for facial paralysis after cerebral ischemic injury, was a candidate for this type of fungal infection. As reported in the literature, one of the factors that could have influenced the appearance of C tropicalis pneumonia in our patient was the risk factors for long-term aspiration.10
Candida infections also depend on the host immune system and risk factors, which might represent a wide spectrum of life-threatening situations such as candidemia, especially in immunocompromised patients and the ones with access to modern invasive medical procedures.11 C tropicalis is prevalent in patients with hematological disorders, especially in those who did not receive prior fluconazole prophylactic treatment before receiving any immunosuppressant, and it also has a greater capacity to induce resistance to therapy.12
Many clinical studies have reported C tropicalis infections in different scenarios, especially in immunocompromised patients undergoing catheterization and prolonged periods of parenteral nutrition. In addition, this infection has been found in patients with certain risk factors such as uncontrolled diabetes mellitus, cancer, as well as treatment with low doses of azoles, which is known to predispose an individual to C tropicalis colonization.13
Early identification and antifungal therapy susceptibility are essential in the patient’s prognosis and mortality. The clinical features of fungal pneumonia are nonspecific, and definitive diagnosis requires cultures, molecular techniques, and fungal histological confirmation of the lung tissue.14 In this cases report, our patient presented with common symptoms of respiratory involvement such as cough, fever, expectoration, and chest pain. However, the final diagnosis was obtained by the isolation of C tropicalis in the sample culture and molecular techniques of the BAL sample.
There are variable virulence factors depending on the infecting Candida species. In this context, it is considered that C tropicalis could be more invasive than other species, especially in immunocompromised hosts. Furthermore, it is associated with a greater capacity to develop resistance to antifungals.15
In any case, C tropicalis infection as a cause of pneumonia is infrequent and requires histological, microbiological, or PCR methods for its demonstration so it may be an exception to the general rule.
In our patient, not a single pathogen bacterium was found by evaluation of the FilmArray respiratory panel and MALDI-TOF Biotyper mass spectrometry. It is known that bacteria and fungi influence each other’s survival and virulence. Some effects may be beneficial, such as probiotic bacteria that decrease fungal colonization, while some may be detrimental, such as mixed-species biofilms, which cause bacteria to attach to the fungal surface or co-aggregate with fungal cells. Various bacteria also produce small molecules that affect fungal morphology thus altering the ability of the fungus to form biofilms or invade tissues.16
Bronchoscopy and BAL provided relevant information, allowing a sample to be obtained for the culture and confirmation of infection by C tropicalis. After the culture result, targeted treatment with caspofungin was used, and a rapid clinical improvement was observed. Oral voriconzol was prescribed to continue with outpatient management.
Conclusion
The presence of severe pneumonia caused due to C tropicalis might occur in specific cases, such as in patients with the risk factors mentioned above. To improve the outcomes in these patients, a fast and accurate diagnosis is required through bronchoscopy sampling, molecular study, histopathology, and culture.
Footnotes
The author(s) declared no potential conflicts of interest with respect to the research, authorship, and/or publication of this article.
Data Availability Statement: A copy of the written consent from each patient is available for review by the Editor-in-Chief of this journal.
The data presented in this case presentation are available on request from the corresponding author.
Funding: The author(s) received no financial support for the research, authorship, and/or publication of this article.
Ethics Approval: The ethics approval was obtained by the hospital’s ethics committee for publication.
Informed Consent: Verbal consent was obtained from the patient involved in the case presentation.
Consent for Participation: Written informed consent was obtained from the patient for publication of this case report and accompanying images. A copy of the written consent is available for review by the editor-in-chief of the journal.
ORCID iD: Killen H. Briones-Claudett
https://orcid.org/0000-0002-7778-0362
References
- 1. Torres A, Niederman MS, Chastre J, et al. International ERS/ESICM/ESCMID/ALAT guidelines for the management of hospital-acquired pneumonia and ventilator-associated pneumonia: guidelines for the management of hospital-acquired pneumonia (HAP)/ventilator-associated pneumonia (VAP) of the European Respiratory Society (ERS), European Society of Intensive Care Medicine (ESICM), European Society of Clinical Microbiology and Infectious Diseases (ESCMID) and Asociación Latinoamericana del Tórax (ALAT). Eur Respir J. 2017;50(3):1700582. doi: 10.1183/13993003.00582-2017 [DOI] [PubMed] [Google Scholar]
- 2. Moss BJ, Musher DM. Candida species in community-acquired pneumonia in patients with chronic aspiration. Pneumonia (Nathan). 2021;13(1):12. doi: 10.1186/s41479-021-00090-x [DOI] [PMC free article] [PubMed] [Google Scholar]
- 3. Masur H, Rosen PP, Armstrong D. Pulmonary disease caused by Candida species. Am J Med. 1977;63(6):914-925. doi: 10.1016/0002-9343(77)90546-0 [DOI] [PubMed] [Google Scholar]
- 4. el-Ebiary M, Torres A, Fàbregas N, et al. Significance of the isolation of Candida species from respiratory samples in critically ill, non-neutropenic patients. An immediate postmortem histologic study. Am J Respir Crit Care Med. 1997;156(2, pt 1):583-590. doi: 10.1164/ajrccm.156.2.9612023 [DOI] [PubMed] [Google Scholar]
- 5. Shoar S, Centeno FH, Musher DM. Clinical features and outcomes of community-acquired pneumonia caused by haemophilus influenza. Open Forum Infect Dis. 2021;8(4):ofaa622. doi: 10.1093/ofid/ofaa622 [Erratum in: Open Forum Infect Dis. 2021;8(6):ofab226.] [DOI] [PMC free article] [PubMed] [Google Scholar]
- 6. Leung AY, Chim CS, Ho PL, et al. Candida tropicalis fungaemia in adult patients with haematological malignancies: clinical features and risk factors. J Hosp Infect. 2002;50(4):316-319. doi: 10.1053/jhin.2002.1194 [DOI] [PubMed] [Google Scholar]
- 7. Yesudhason BL, Mohanram K. Candida tropicalis as a predominant isolate from clinical specimens and its antifungal susceptibility pattern in a tertiary care hospital in Southern India. J Clin Diagn Res. 2015;9(7):DC14-DC16. doi: 10.7860/JCDR/2015/13460.6208 [DOI] [PMC free article] [PubMed] [Google Scholar]
- 8. Yang YL, Ho YA, Cheng HH, et al. Susceptibilities of Candida species to amphotericin B and fluconazole: the emergence of fluconazole resistance in Candida tropicalis. Infect Control Hosp Epidemiol. 2004;25(1):60-64. doi: 10.1086/502294 [DOI] [PubMed] [Google Scholar]
- 9. Arendrup MC. Candida and candidaemia. Susceptibility and epidemiology. Dan Med J. 2013;60(11):B4698. [PubMed] [Google Scholar]
- 10. Deorukhkar SC, Saini S, Mathew S. Virulence factors contributing to pathogenicity of Candida tropicalis and its antifungal susceptibility profile. Int J Microbiol. 2014;2014:456878. doi: 10.1155/2014/456878 [DOI] [PMC free article] [PubMed] [Google Scholar]
- 11. Sardi JCO, Scorzoni L, Bernardi T, et al. Candida species: current epidemiology, pathogenicity, biofilm formation, natural antifungal products and new therapeutic options. J Med Microbiol. 2013;62(pt 1):10-24. doi: 10.1099/jmm.0.045054-0 [DOI] [PubMed] [Google Scholar]
- 12. Sim JP, Kho BC, Liu HS, et al. Candida tropicalis arthritis of the knee in a patient with acute lymphoblastic leukaemia: successful treatment with caspofungin. Hong Kong Med J. 2005;11(2):120-123. [PubMed] [Google Scholar]
- 13. Kothavade RJ, Kura MM, Valand AG, et al. Candida tropicalis: its prevalence, pathogenicity and increasing resistance to fluconazole. J Med Microbiol. 2010;59(pt 8):873-880. doi: 10.1099/jmm.0.013227-0 [DOI] [PubMed] [Google Scholar]
- 14. Kontoyiannis DP, Reddy BT, Torres HA, et al. Pulmonary candidiasis in patients with cancer: an autopsy study. Clin Infect Dis. 2002;34(3):400-403. doi: 10.1086/338404 [DOI] [PubMed] [Google Scholar]
- 15. Anil S, Hashem M, Vellappally S, et al. Sub-inhibitory concentrations of antifungals suppress hemolysin activity of oral Candida albicans and Candida tropicalis isolates from HIV-infected individuals. Mycopathologia. 2014;178(3-4):207-215. doi: 10.1007/s11046-014-9802-0 [DOI] [PubMed] [Google Scholar]
- 16. Azoulay E, Timsit JF, Tafflet M, et al. Outcomerea Study Group. Candida colonization of the respiratory tract and subsequent pseudomonas ventilator-associated pneumonia. Chest. 2006;129(1):110-117. doi: 10.1378/chest.129.1.110 [DOI] [PubMed] [Google Scholar]
